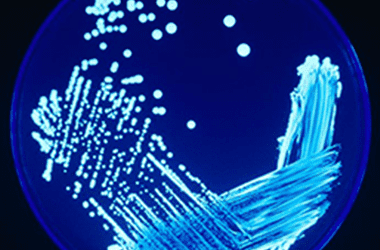

There could be a hidden risk in your water system that can lead to a harmful pneumonia called legionnaires disease if left unmanaged. Anyone in control of blocks of flats has a duty to manage the risk. Read on to find out more about legionella and what you need to do with advice from Dr Shaun Lundy, Technical Director at 4site Consulting.
What is Legionella?
Legionella was discovered after an outbreak in 1976 among people who went to a Philadelphia convention of the American Legion. Those who were affected suffered from a type of pneumonia (lung infection) that eventually became known as Legionnaires’ disease. The bacterium Legionella pneumophila originates from natural water sources such as rivers and lakes. The disease is a form of Pneumonia and can be fatal. Some of the symptoms associated with Legionnaire’s disease include: coughing, shortness of breath and chest pains.
How does Legionnaire’s Disease Spread?

Legionnaire’s disease is usually contracted through the inhalation of small droplets of contaminated water. It is most commonly spread by domestic fittings such as: hot and cold-water systems, showers, whirlpool baths, air conditioning systems and cooling towers. The usually naturally occurring Legionella species can thrive in purpose-built, man-made systems between the temperatures of 20-45°C. This is more likely to occur if the water is stagnant (doesn’t flow) and provides a source of nutrients for the Legionella bacteria. There is no evidence to suggest that Legionnaire’s disease is contagious from person to person.
Who is Most at Risk?
Everyone is at risk however there are some factors which make people more at risk of contracting Legionnaire’s disease than others. Those who are regular smokers and drinkers are at higher risk of become infected with Legionnaire’s disease; alongside those over 45 years’ old. Additionally, people who have existing medical conditions such as; diabetes, lung disease, heart disease, kidney disease, respiratory illnesses and weakened immune systems are more likely to contract the disease. Remarkably, men are more likely to become infected with Legionnaire’s disease and are affected more severely than women.
It is important to remember that, although the vulnerable may be at higher risk, anybody can be susceptible to infection of Legionnaire’s disease and it should be taken very seriously.
What are the Legal Duties

Duties under the Health and Safety at Work etc Act 1974 (HSWA) extend to risks from legionella bacteria. More specifically, the Control of Substances Hazardous to Health Regulations 2002 (COSHH) provide a framework of actions designed to assess, prevent or control the risk from bacteria like Legionella and take suitable precautions. The Approved Code of Practice (ACOP): Legionnaires’ disease: The control of Legionella bacteria in water systems (L8) contains practical guidance on how to manage and control the risks in your system. Basically, the duty is to conduct a risk assessment and prevent exposure to legionella. Where prevention is not possible there must adequate controls put in place to reduce the risk and these must be maintained.
4 Simple Steps to Manage the Risk from Legionella
1. Identify and Assess the Risk.
The first step towards ensure your property is safe from Legionnaire’s disease is to identify and assess the risk of Legionella. It is a legal duty for Landlords to assess the risk of Legionella exposure in their properties, and also to control this risk. A Legionella Risk Assessment should be carried out by a competent person, perhaps an external consultancy, who will have in-depth knowledge and experience in carrying out assessments in residential property.
2. Manage the Risk.
Once the risk of Legionella in your property has been identified and assessed, the second step in the process is to begin the process of managing the risk. The Health & Safety Executives ACOP L8 requires that the Duty Holder should appoint a legionella ‘Responsible Person’ to take day-to-day responsibility for controlling Legionella bacteria and Legionnaires’ disease. This will involve implementing the recommendations from the risk assessment, selecting contractors to maintain the system and arranging for routine monitoring as required.
3. Prevention and Control
It is important to note that the spread of Legionnaire’s disease is very much preventable. The best way to prevent legionella is to reduce the amount of stored water.
The HSE describe a typical ‘low risk’ example as a small domestic-type water system, where daily water usage is sufficient to turn over the entire system; where cold water is directly from a wholesome mains supply (no stored water tanks); where hot water is fed from instantaneous heaters or low volume water heaters (supplying outlets at 50 °C); and where the only outlets are toilets and wash hand basins.
Higher risk systems are more complex, with stored water, low levels of flow and temperatures of between 20-45°C. The best approach to prevent the risk is by eliminating the conditions that allow legionella bacteria to grow and disperse. Where the risk cannot be prevented through elimination it must be adequately controlled. One of the main ways to do this is to control the temperature. Low temperatures (under 20°C) allow the bacteria to survive but prevent them from multiplying, temperatures over 60°C cause the bacteria die. Other control strategies can involve reducing the release of water spray, keeping the water and the system clean, and ensuring there is enough flow to prevent the water from going stagnant.
Other things you should consider as part of the prevention and control strategy are:
- Flushing out and cleaning the system when the opportunity arises.
- Avoiding debris getting into the system by ensuring the cold-water tanks, where fitted, have a tight-fitting lid and are inspected regularly.
- Make sure any redundant pipework is identified during the risk assessment and is removed to prevent the stagnant water there from infecting the rest of the system (typically known as dead-legs).
The risk is further lowered where instantaneous water heaters (for example combi boilers and electric showers) are installed because there is no water storage.
4. Keep Records.
If you have had a risk assessment completed you must keep a record of it so that you can evidence the actions taken to eliminate or reduce the risk. Maintaining a water log book for the building can be a useful way of recording water temperatures and other checks to demonstrate that you are managing risks appropriately.
What Residents Needs to Know

Residents should be advised of any control measures put in place that should be maintained e.g. Keep the temperature setting of the calorifier (water heater) at 60 °C, to regularly clean showerheads and inform the landlord of any other problems with the system so that appropriate action can be taken.
Where showers are installed, these have the means of creating and dispersing water droplets (aerosols) which may be inhaled causing a foreseeable risk of exposure to Legionella. If used regularly (as in the majority of most domestic settings) the risks are reduced, however it is good advice to regularly clean and disinfect showerheads especially if they remain unused for longer periods of time. Instantaneous electric showers pose less of a risk as they are generally cold water-fed and heat only small volumes of water during operation.
Additional Actions for Properties Left Vacant

It is important that water is not allowed to stagnate within the water system and so there should be careful management of properties left vacant for extended periods. This can be a difficult area to manage as landlords have little control over leasehold demised areas. As a general principle, outlets on hot and cold-water systems should be used at least once a week to maintain a degree of water flow and minimise the chances of stagnation. To manage the risks during non-occupancy, consideration should be given to implementing a suitable flushing regime or other measures such as draining the system if it is to remain vacant for long periods.
Conclusion
Make sure you know your water system and any potential risks that it may create. Get a risk assessment done if you haven’t already done so and consider how you can eliminate the conditions that may allow legionella to thrive. Identify any control measures needed to manage any residual risks and keeps records of any sampling, temperature checks, flushing regimes or general maintenance of the system. Keep records of your risk controls measures to demonstrate compliance. Finally, consider providing residents with information and advice on legionella control so they can manage any risks within their demised areas.